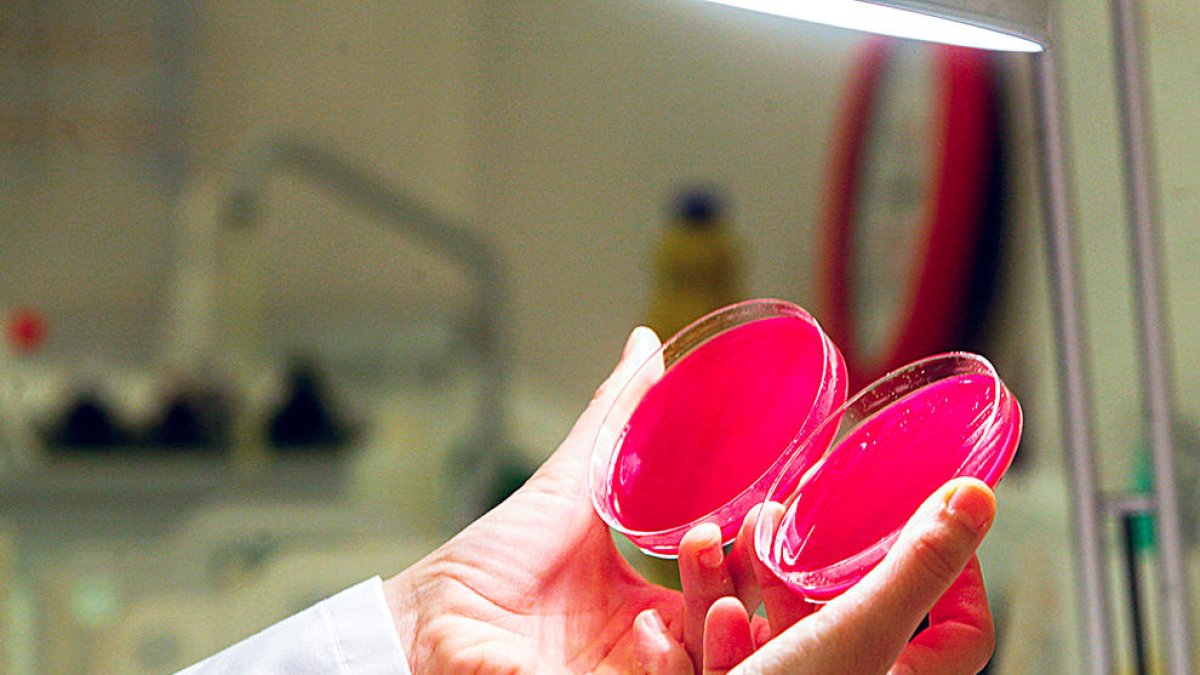
La Xina, els Estats Units, Japó i l'OMS fan assajos clínics per trobar una cura

pandèmia mundial
La Xina, els Estats Units, Japó i l'OMS fan assajos clínics per trobar una cura
La vacuna podria ser la solució més factible però el procés es pot allargar un any
La Xina, els Estats Units, Japó i l'OMS fan assajos clínics per trobar una cura
La crisi sanitària generada per la ràpida propagació de la Covid-19 i el seu impacte en l’economia mundial està iniciant una lluita entre la indústria biofarmacèutica entre els països per trobar un tractament, sigui vacuna o altres teràpies, que puguin combatre la pandèmia. De fet, la Xina va anunciar ahir el començament d’assajos clínics amb humans d’una vacuna contra el coronavirus, desenvolupada per l’Acadèmia Militar de Ciències, tot i que s’haurà d’esperar encara uns mesos per a l’ús massiu. Aquesta notícia va ser donada poques hores després que Washington comuniqués també l’inici, per la seva banda, de les proves amb humans d’una vacuna.
És que aquests dos països, la Xina i els Estats Units, són els pioners que han iniciat les primeres proves per trobar una vacuna, tot i que també s’estant buscant altres mètodes que puguin ser la solució. En aquests moments els científics han pogut demostrar que les persones infectades tenen anticossos per evitar la unió del virus a unes cèl·lules que es troben a les vies respiratòries, provocant la malaltia. La dificultat, però, és que una vacuna que ho aturi és un procés que podria tardar més d’un any a aconseguir-se. Malgrat això, es creu que podria ser una de les solucions més eficients. La segona opció trobada fins ara és un fàrmac, el qual la japonesa Takeda està creant, derivat del plasma sanguini per tractar els individus d’alt risc amb Covid-19.
Per altra banda, l’Organització Mundial de la Salut (OMS) ahir també va anunciar la posada en funcionament d’un gran assaig clínic en l’àmbit mundial per comprovar quin és el tractament més eficaç per combatre el coronavirus, que en aquests moments ja compta amb més de 200.000 contagiats i 8.000 morts.
El director general de l’OMS, Tedros Adhanom Ghebreyesus, va informar que en aquest estudi participaran deu països sota el nom de Solidarity, entre els quals es troben Espanya i França. Aquesta decisió va ser presa ja que hi ha múltiples assajos clínics amb diferents mètodes, i per tant Tedros va assegurar que “d’aquesta manera no se’ns pot donar la clara i forta evidència de quin és el que necessitem per ajudar a salvar vides”.
Mentrestant, el director general va interpel·lar a la necessitat de confinar-se sempre que sigui possible per tal de reduir la possibilitat de contagiar-se.
ALTERNATIVA AL PCR
Adrià Esteban - Andorra la Vella a recerca biomèdica s’obre espai en la crisi del coronavirus a través de la seqüenciació dels genomes. Un grup d’investigadors valencians va poder obtenir ahir, a partir de l’extracció de l’ADN de pacients infectats per la Covid-19, les primeres dades que permeten traçar les vies de transmissió de la malaltia. Precisament és el que proposa David Vilanova, un bioinformàtic que va oferir-se al SAAS a través de Twitter per interpretar, “de forma altruista”, la lectura de dades que analitza el seqüenciador de MiniON, un innovador programa informàtic d’Oxford Nanopore Technologies. “La PCR el que fa només és identificar el virus i et diu si la prova és negativa o positiva. L’anàlisi metagenòmica el que permet és identificar tot el que hi ha allà: virus, bacteris, fongs...”, sosté Vilanova. D’aquesta manera, considera que ambdós mecanismes són “complementaris” en la lluita contra la pandèmia, tot i que recalca que mitjançant la seqüenciació dels genomes es pot arribar a establir un seguiment epidemiològic a partir de la cadena d’ADN. “El coronavirus va mutant i aleshores es pot traçar a nivell genòmic i a quin pacient correspon. Per exemple, el pacient 31 a Corea del Sud va infectar 1.000 persones. Ho van saber perquè van fer una anàlisi de l’ADN”, va dir. Fins ara, els casos de sospita de Covid-19 d’Andorra són analitzats als laboratoris de Majadahonda (Madrid), però, tenint en compte el pic d’infeccions i el col·lapse del sistema sanitari del país del sud, el Govern està en espera d’adquirir, previsiblement a final de mes, la prova del PCR per agilitzar el termini de detecció de la malaltia, que dura aproximadament unes 24 hores. “Amb la màquina per fer la seqüenciació de genomes el procés es pot fer en set hores. Jo podria gestionar unes 300 mostres al dia en l’àmbit informàtic. La part més crítica és l’extracció d’ADN, en la qual es necessiten mans a nivell de laboratori”, va expressar Vilanova. Per aquest motiu, el bioinformàtic va suggerir l’aposta d’aquesta tecnologia al laboratori de microbiologia de l’hospital. “El kit complet val uns 4.000 euros, però si l’hospital tingués aquesta tecnologia seria menys depenent del que vingui d’altres laboratoris de fora”, va esgrimir. No obstant això, Vilanova va reivindicar la seva implementació com “una necessitat que va més enllà del coronavirus”, ja que “té una aplicació molt àmplia en malalties infeccioses”.